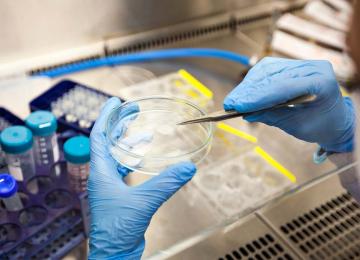

A domestic knowledge-based company has produced nanomicelle capsules with the therapeutic effects of turmeric, which have anti-inflammatory, antioxidant and cancer-prevention properties.…
Sci & Tech
The speed of the fixed wireless internet has increased in the first month of 2023 compared to the previous month, while that of mobile network has continued to decline further, according to the…
Domestic experts have produced an Earth Crust Movement Monitoring System based on the Global Positioning System to reduce the destructive impacts of earthquakes. The system can monitor…
A knowledge-based company has developed an environment-friendly method to increase the resistance of metallic equipment and parts to corrosion by using a nanocoating.
Two domestic companies have developed nanotech-based car components, leading to highly durable car lights and longer-lasting car batteries.
A domestic engineering company has produced a machine that can make electronic components waterproof. The Industrial Plasma Treatment Machine, produced by Basafan Engineering Company, lends…
Telecom and mobile operator Irancell inaugurated several expansion projects last week.
A knowledge-based company has produced a smart self-healing asphalt (also known as rubber bitumen) that is cheaper than foreign counterparts. The smart asphalt improves the quality of roads,…
Researchers of the Human and Animal Cell Bank of the Iranian Biological Resource Center have introduced mitochondrial genes (the cell's energy production factory) as molecular markers for…
Domestic researchers have produced a unique hybrid mill that creates nanopowder from different substances for use in research centers and industries.
The number of products and equipment based on nanotechnology in Iran has increased sixfold in a nine-year period, according to the latest data released by the Nanotechnology Development…
A domestic knowledge-based company has produced a nano-based product that can be used to detect drug sensitivity. The product, based on nanotechnology, is used to identify the appropriate…
A total of 580 new ideas in the form of research projects, technological knowhow, knowledge-based products and master's and doctoral theses have been registered in the new Ideas and Needs System…
A knowledge-based company has recently received an international patent certificate for a medicine that reduces the side-effects of Covid-19.
A domestic knowledge-based company has produced different types of high quality and long lasting V-belts that have wide applications in industries. Basically used to transfer power from one…
A knowledge-based company has used nanotechnology to produce a concrete flooring that offers a superior alternative to ordinary concrete flooring.
The Speedtest web service in its latest survey on internet speed worldwide said the speeds of both Iranian fixed and mobile networks have declined in November compared to the previous month.
A domestic knowledge-based company has developed a search engine that has exclusive features for Iranian users in Persian. “The domestic search engine named Sin Jim can be a good complement to…
A domestic knowledge-based company has produced a high quality bandsaw metal cutting machine that is cheaper than its foreign counterparts. The bandsaw cutting machine is used to cut different…
A total of 8,735 knowledge-based companies are active in the country, according to the Deputy Science, Research and Technology Minister Ali Khaireddin.
A knowledge-based company has developed a geoinformatics system to improve the quality of rescue missions. The system, developed by Kavosh Sepehr Lotus Company, helps rescue forces predict the…
A domestic knowledge-based company has produced an engine cleaner that prevents oxidation caused by traditional engine-washing methods. The engine cleaner uses nanotechnology to ensure parts…
A domestic company has produced a cartoning machine that can handle fragile products and speeds up the packaging process in industries.
A domestic knowledge-based company has developed a smart device to help visually-impaired people surf the internet in the most optimal way. The screen reader makes it possible to read the text…
SpaceX has received the permission to start building the next generation of its Starlink internet mega-constellation. On Dec. 1, the US Federal Communications Commission approved the deployment…